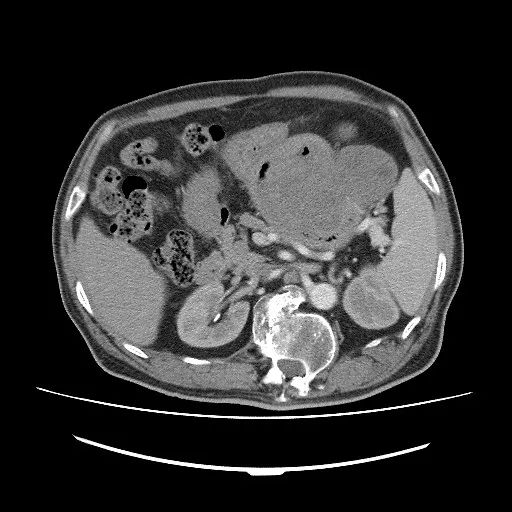
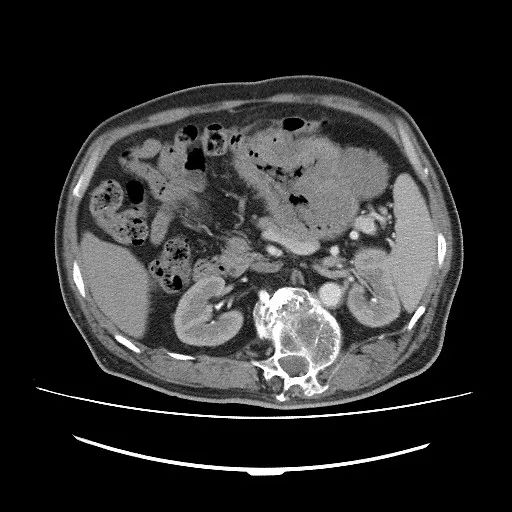

病史
男,68岁。胃部胀痛不适2月余,查体:锁骨上未触及肿大淋巴结,双肺呼吸音清晰,未闻及啰音,心率80次/分,律齐,心音有力,未闻及杂音,腹部平坦,未见胃肠型及蠕动波,腹部软,上腹部压痛,反跳痛及肌紧张,肝脾未及,未触及腹部包块,叩鼓音,肝区及双肾区无叩击痛,肠鸣音正常存在。双下肢无水肿。

钡餐检查:病灶呈球形或者半球形的充盈缺损,且大小不一,且能够发现明显的黏膜破坏,龛影及黏膜平坦等征象,能够观察较大的腔外型包块诱发的外压性改变;如果肿瘤边界不清,邻近胃肠道黏膜纠集则提示恶性。GI还能动态观察胃蠕动的情况,观察轮廓的改变,对于龛影和充盈缺损的显示优于CT。小肠间质瘤均有不同程度的肠黏膜局限性消失、破坏,若仅累及一侧肠壁,可造成肠腔偏心性狭窄。当GIST腔外生长呈结节状肿块时,GI检查较难发现。
CT检查:CT扫描能够对GI无法完整显示的向腔外生长肿瘤的形态,大小清晰显示,尤其是多期增强扫描除了可以清晰的显示胃肠道管腔、管壁及肿块的形态外,还可以同时对管腔内的情况进行观察。扫描主要表现为胃肠道壁局限性增厚及软组织肿块,肿块呈圆形或分叶状,肿块大小多为4.5~8.5cm,随肿块增大,出现坏死、囊变或钙化率增高,导致密度不均匀,增强检查实性软组织成分多呈中度或明显强化,坏死囊变区无强化,肿瘤与周围组织器官界限模糊,可见存在侵袭性,如发生转移则支持恶性GIST。
CT检查特点:增强扫描肿瘤实质部分动脉期即有明显强化,静脉期持续强化,囊性部分无强化,静脉期强化可比动脉期更显著,坏死、囊变区无强化。
MRI表现:GIST肿块信号不均匀,T1WI以低信号为主,T2WI以高信号为主,内部液化坏死区T1WI低信号,T2WI高信号,增强扫描肿块中度不均匀强化,坏死区无强化。
鉴别诊断
GIST 主要与以下疾病相鉴别:
①胃癌:胃癌起源于胃黏膜上皮,腔内生长型胃癌沿黏膜及黏膜下浸润生长,造成黏膜破坏、中断,局部形成胃壁肿块,肿块多不规则,表面常呈菜花状,肿块于邻近组织界限不清,常发生淋巴转移,与少见的外生性胃腺癌不同的关键在于肿块周围胃壁黏膜常增厚,且常常导致胃出口梗阻,CT和MR增强均明显强化,而且强化峰值时间早,而GIST常见局部境界清晰的软组织密度肿块,黏膜连续,极少发生淋巴转移。
②胃和小肠的淋巴瘤:管壁明显不规则增厚,最厚处>25cm,而且范围广泛,向黏膜下浸润,增厚胃壁浆膜面光滑,可见多发淋巴结肿大。
③平滑肌瘤和神经源性肿瘤:多<5cm,胃内型和胃壁型多见,鉴别困难,病理上平滑肌肿瘤CD117和CD34呈阴性,可以鉴别。
④腺瘤型息肉:起源于黏膜的隆起性病变,好发于幽门和胃体,移动度大。
【病理结果】
胃肠道间质瘤(gastrointestinal stromal tumors,GIST)是一组独立起源于胃肠道原始间叶组织的肿瘤,有别于胃肠道肌源性或神经源性的肿瘤。大部分学者认为GIST肿瘤起源于间叶干细胞,是一种具有恶性潜能的胃肠道肿瘤,具有不定向分化的多向分化特征。临床症状出现晚且无特异性。其早期临床表现不典型,主要表现为腹部不适、腹部包块、腹痛、消化道出血、便血、溃疡或贫血等,也有许多患者无明显的临床表现。它起源于胃肠道黏膜下间叶组织,可发生于从食管至肛门的任何区域,也可发生于胃肠道外的肠系膜、网膜、后腹膜。该病在中老年人群中具有较高的发病率,流行学显示患者年龄为50~65岁。95%的GIST原发在胃肠道,最常见的好发部位是胃(60%~70%)、小肠(20%~30%)、大肠(<5%)、其他部位如肠系膜、网膜和后腹膜的病变不足5%。
病理表现 该类肿瘤细胞主要为梭形细胞和/或上皮样细胞,光镜下似平滑肌样细胞,以往常称之为平滑肌瘤及肉瘤。肿瘤多呈膨胀性生长,可向腔外、腔内或腔内外混合生长,常有不同程度的坏死、囊变,坏死、囊变明显时肿瘤可呈囊样病灶,内部可积气、积液并合并感染。
 纵隔大细胞神经内分泌癌1例CT影像
纵隔大细胞神经内分泌癌1例CT影像  张力性纵隔气肿影像表现及严重度分级
张力性纵隔气肿影像表现及严重度分级  迅速增大的肺部结节,首先考虑良性,确诊需要肺穿
迅速增大的肺部结节,首先考虑良性,确诊需要肺穿  肺隔离症:易误诊为肺癌的占位性病变,肺穿刺禁忌!
肺隔离症:易误诊为肺癌的占位性病变,肺穿刺禁忌!  肺段与肺内管道应用解剖
肺段与肺内管道应用解剖  肺转移瘤的十种不典型CT表现
肺转移瘤的十种不典型CT表现  肺内淋巴结的CT表现特点及与病理对照
肺内淋巴结的CT表现特点及与病理对照  肺实变与肺不张的CT鉴别诊断
肺实变与肺不张的CT鉴别诊断  医生现身说法,这五种忙帮不得!
医生现身说法,这五种忙帮不得!  北大教授:要真正让医务人员有阳光体面的收入!医
北大教授:要真正让医务人员有阳光体面的收入!医  为值夜班的医生护士鼓与呼:请给我们更多关注!
为值夜班的医生护士鼓与呼:请给我们更多关注!  广东拟取消医院用药数量限制,满足患者多样性需求
广东拟取消医院用药数量限制,满足患者多样性需求  博士、硕士入职就给精装房!又有医院不惜下血本招
博士、硕士入职就给精装房!又有医院不惜下血本招  历时7年之久,温医生宣判无罪!
历时7年之久,温医生宣判无罪!  重磅!四川发文:严禁限制医生多点执业
重磅!四川发文:严禁限制医生多点执业  与真人医生诊断一致性达96%:AI医生应用前景广阔
与真人医生诊断一致性达96%:AI医生应用前景广阔 



